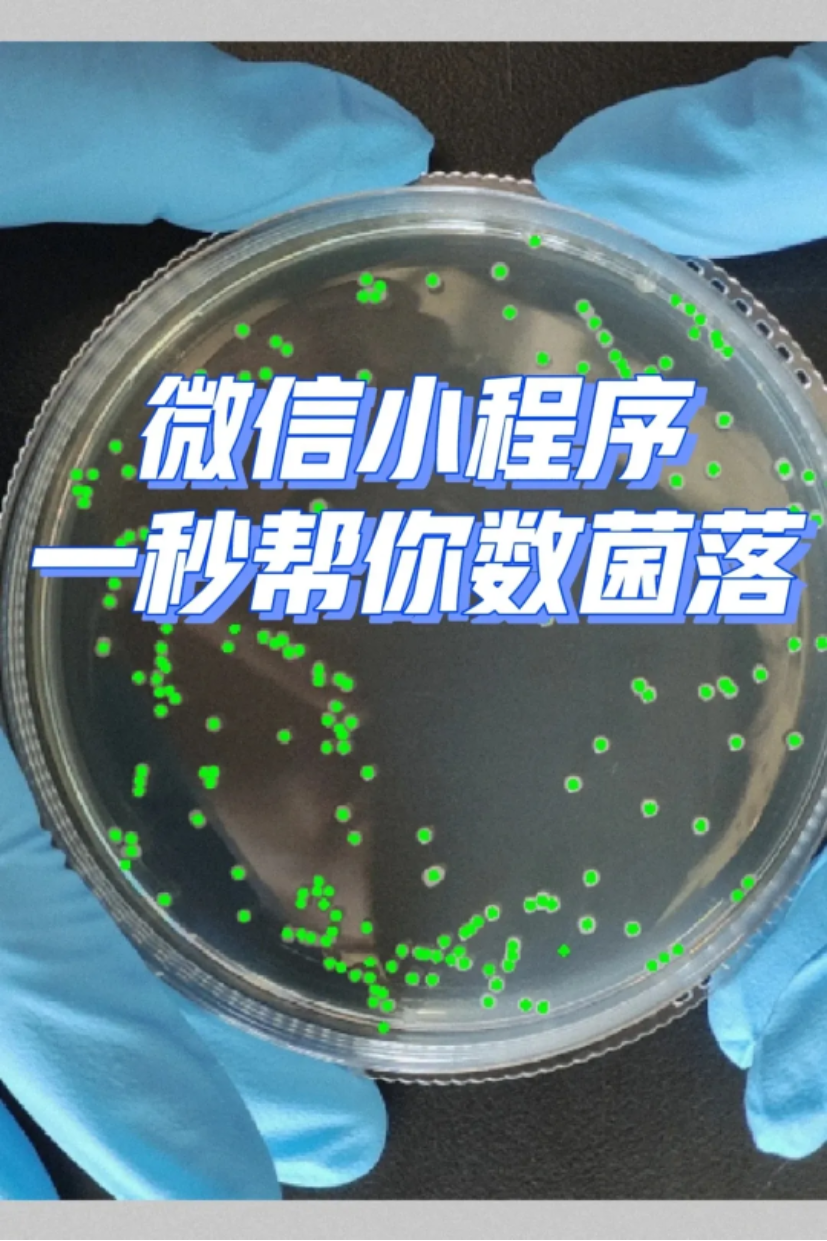

深夜实验室
实验室好物分享
大家晚上好呀!
本期深夜实验室,我们采访收集了一些有趣的够提升实验效率、甚至增添工作乐趣的实验室好物。
假如你正在为一些实验过程中遇到的小麻烦而感到烦恼,又或是想要寻找一些提高实验室工作效率的秘密武器,那接下来的分享就一定不容错过。
1耐高温灭菌袋
实验室中总是有各种实验器材需要进行灭菌处理,耐高温灭菌袋提供了一个简单而有效的解决方案。
耐高温灭菌袋不仅能够承受住高达121℃至135℃的高压蒸汽灭菌处理,同时也能保证灭菌后袋内物品的无菌状态。同时,灭菌袋的透明度高,便于我们对带内物品进行查找。

此外,这类灭菌袋的封口牢固,可以有效防止带内物品泄漏。
我们有多种规格的灭菌袋可以选择,来适应不同尺寸物品的灭菌需求。
2点数相机
相信对每一个生物人来说,菌落的计数都是一个非常繁琐且枯燥的过程。尤其是平板上的菌落又小又多的时候,手动点数不仅耗时,还需要非常专注,如遇打扰,就容易前功尽弃。
点数相机采用人工智能技术,能够准确识别并计数菌落,仅需通过拍照,就能快速清点出照片中菌落的数量,大幅提升了计数效率。
点数相机还能自动记录清点好的菌落数量,方便后续的数据记录和分析。除了菌落计数,点数相机还适用于其他多种物品的计数,如钢管、钢筋、方木等,具有广泛的应用场景。
3标签打印机
在实验室中,面对众多的瓶瓶罐罐、盒盒袋袋,区分它们可能会成为一个难题。这时,我们可以使用标签打印机打印的标签来对它们进行区分。

标签打印机打印可以帮助大家快速、准确地创建清晰且持久的标签,标签上除了物品名称外,还可以快速插入试剂开启时间,使用者,实验组等信息。
4带轮购物篮
在实验过程中有时需要我们频繁搬运实验物品,这是,我们双手有限的携带能力往往会导致效率低下。带轮购物篮以其便携性和容量大的特点,为这一问题提供了巧妙的解决方案。
带轮购物篮设计有较大的存储空间,可以一次性装载较多的物品,减少往返次数。同时,滚轮提供了良好的机动性,也让我们能更加轻松地搬运较重的物品。

用购物框搬运易碎的玻璃瓶等物品,也一定程度上减少了我们在搬运途中不慎将实验器材打碎的风险。
5“拍照片神器”拷贝台
画画时使用的拷贝台能够提供均匀的背光,当我们把它用于拍摄透射材料时,会使影像更加清晰。同时,背光效果能够增强照片的细节和质感,使得作品的细微之处得到突出。

在拍摄过程中,拷贝台的光线可以消除因光照不均而产生的阴影,使得拍摄结果更加均匀。
随着本期分享的落幕,我们希望今晚带来的每一件好物都能在同学们未来的科研生活中发挥它的独特价值,陪伴着我们度过每一个实验时光,助力我们在科研的道路上不断前行。
END
排版 | 赵昕盟
文案|和玥昕,赵昕盟
指导老师 | 陈曼
审核 | 常非